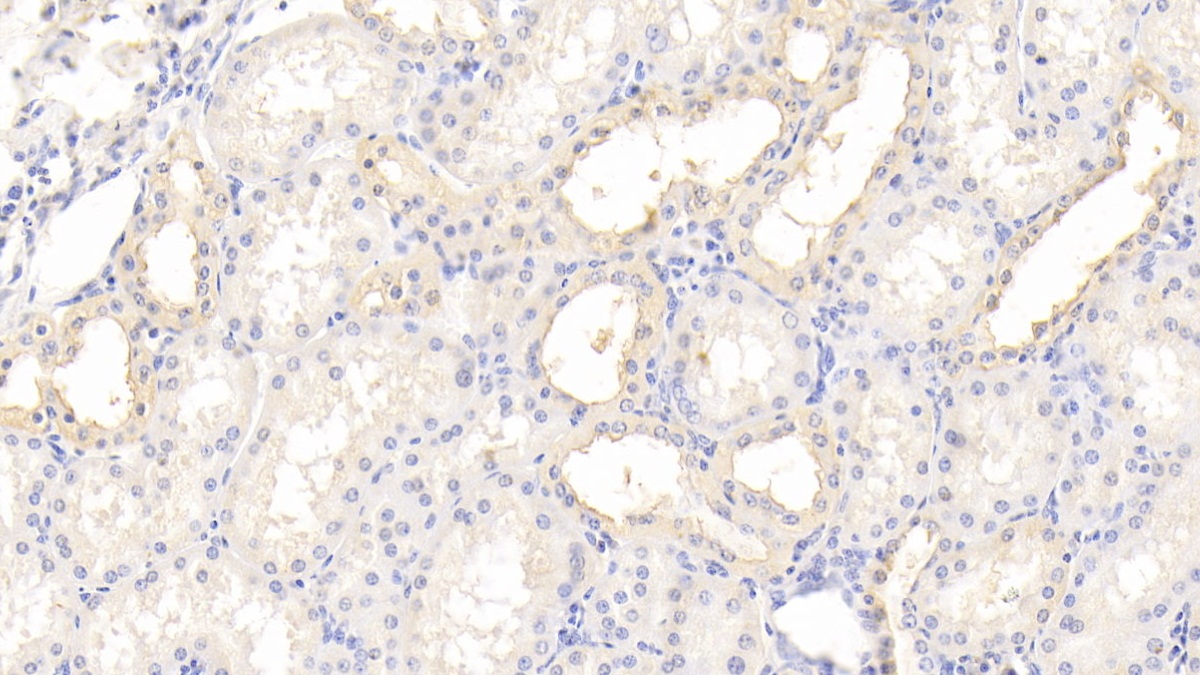

Polyclonal Antibody to Tissue Inhibitors Of Metalloproteinase 3 (TIMP3)
SFD; TIMP Metallopeptidase Inhibitor 3; Metallopeptidase Inhibitor 3; Sorsby Fundus Dystrophy; Pseudoinflammatory
- Product No.PAA129Hu01
- Organism SpeciesHomo sapiens (Human) Same name, Different species.
- SourcePolyclonal antibody preparation
- HostRabbit
- Potencyn/a
- Ig Type IgG
- PurificationAntigen-specific affinity chromatography followed by Protein A affinity chromatography
- LabelNone
- Immunogen RPA129Hu01-Recombinant Tissue Inhibitors Of Metalloproteinase 3 (TIMP3)
- Buffer FormulationPBS, pH7.4, containing 0.02% NaN3, 50% glycerol.
- TraitsLiquid
- Concentration0.38mg/mL
- Organism Species MoreMus musculus (Mouse), Rattus norvegicus (Rat)
- ApplicationsWB; IHC; ICC/IF
If the antibody is used in flow cytometry, please check FCM antibodies. - DownloadInstruction Manual
- UOM 20µl100µl 200µl 1ml 10ml
- FOB
US$ 95
US$ 221
US$ 316
US$ 790
US$ 3160
For more details, please contact local distributors!
SPECIFITY
The antibody is a rabbit polyclonal antibody raised against TIMP3. It has been selected for its ability to recognize TIMP3 in immunohistochemical staining and western blotting.
USAGE
Western blotting: 0.01-5µg/mL;
Immunohistochemistry: 5-50µg/mL;
Immunofluorescence: 5-50µg/mL;
Optimal working dilutions must be determined by end user.
STORAGE
Store at 4°C for frequent use. Stored at -20°C in a manual defrost freezer for two year without detectable loss of activity. Avoid repeated freeze-thaw cycles.
STABILITY
The thermal stability is described by the loss rate. The loss rate was determined by accelerated thermal degradation test, that is, incubate the protein at 37°C for 48h, and no obvious degradation and precipitation were observed. The loss rate is less than 5% within the expiration date under appropriate storage condition.
GIVEAWAYS
INCREMENT SERVICES
-
 Antibody Labeling Customized Service
Antibody Labeling Customized Service
-
 Protein A/G Purification Column
Protein A/G Purification Column
-
 Staining Solution for Cells and Tissue
Staining Solution for Cells and Tissue
-
 Positive Control for Antibody
Positive Control for Antibody
-
 Tissue/Sections Customized Service
Tissue/Sections Customized Service
-
 Phosphorylated Antibody Customized Service
Phosphorylated Antibody Customized Service
-
 Western Blot (WB) Experiment Service
Western Blot (WB) Experiment Service
-
 Immunohistochemistry (IHC) Experiment Service
Immunohistochemistry (IHC) Experiment Service
-
 Immunocytochemistry (ICC) Experiment Service
Immunocytochemistry (ICC) Experiment Service
-
 Flow Cytometry (FCM) Experiment Service
Flow Cytometry (FCM) Experiment Service
-
 Immunoprecipitation (IP) Experiment Service
Immunoprecipitation (IP) Experiment Service
-
 Immunofluorescence (IF) Experiment Service
Immunofluorescence (IF) Experiment Service
-
 Buffer
Buffer
-
 DAB Chromogen Kit
DAB Chromogen Kit
-
 SABC Kit
SABC Kit
-
 Long-arm Biotin Labeling Kit
Long-arm Biotin Labeling Kit
-
 Real Time PCR Experimental Service
Real Time PCR Experimental Service
| Magazine | Citations |
| Neuroimmunomodulation | Upregulated Expression of Matrix Metalloproteinases and Tissue Inhibitors of Matrix Metalloproteinases in BALB/c Mouse Brain Challenged with Japanese Encephalitis Virus Pubmed: source |
| Experimental Biology and Medicine | Acidic pH conditions mimicking degenerative intervertebral discs impair the survival and biological behavior of human adipose-derived mesenchymal stem cells Rsmjournals: Source |
| PLoS ONE | A Combinatorial Relative Mass Value Evaluation of Endogenous Bioactive Proteins in Three-Dimensional Cultured Nucleus Pulposus Cells of Herniated Intervertebral Discs: Identification of Potential Target Proteins for Gene Therapeutic Approaches Plosone: Source |
| Physiol. Res. | The unwounded skin remodeling in animal models of diabetes types 1 and 2. Pubmed: 24020818 |
| VirusDisease | Circulating levels of matrix metalloproteinases and tissue inhibitors of matrix metalloproteinases during Japanese encephalitis virus infection Pubmed:26925446 |
| Acta Pharmacol Sin. | Pharmacological evidence: a new therapeutic approach to the treatment of chronic heart failure through SUR2B/Kir6.1 channel in endothelial cells. pubmed:27890915 |
| Biochemical genetics | Comparison of Selected Protein Levels in Tumour and Surgical Margin in a Group of Patients with Oral Cavity Cancer pubmed:28421310 |
| International Journal of Cancer | Circulating and tissue IMP3 levels are correlated with poor survival in renal cell carcinoma Pubmed: 30650187 |
| J. Pers. Med | Altered TIMP-3 Levels in the Cerebrospinal Fluid and Plasma of Patients with Alzheimer's Disease Pubmed:35629249 |